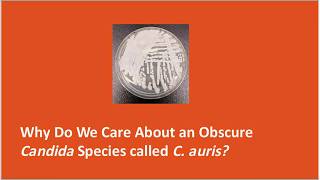

Candida auris Emergence – Dr M Chayakulkeeree video
Online izle ve mp4 mp3 formatlarinda yukle

Videonun muddeti: 12:38
Candida auris Emergence – Dr M Chayakulkeeree videosu mp4 ve mp3 yuklemek ucun hazirdir
Diqqet! Siz Mp4 yukle ve ya Mp3 yukle duymesine basdiqdan sonra eger sistem sizi reklam sehifesine atarsa o zaman derhal geri qayidib emeliyyati tekrar edin ve faylin yuklemek ucun hazir olmasini gozleyin
Videodan Mp4 Yukle
Videodan Mp3 Yukle-1
Videodan Mp3 Yukle-2
Oxshar Axtarishlar
 Candida auris Emergence – Dr M Chayakulkeeree
Candida auris Emergence – Dr M Chayakulkeeree Stopping the Spread of a Superfungus in Intensive Care - Dr Katie Jeffery and Dr David Eyre
Stopping the Spread of a Superfungus in Intensive Care - Dr Katie Jeffery and Dr David Eyre Candida auris: a cause for concern
Candida auris: a cause for concern Candida Auris
Candida Auris CIDRAP ASP - Candida auris, an EmergingMulti-drug Resistant Yeast
CIDRAP ASP - Candida auris, an EmergingMulti-drug Resistant Yeast Your Hospital's Next Global Outbreak
Your Hospital's Next Global Outbreak Candida auris outbreak: The Asian scenario by Prof Chakrabarti
Candida auris outbreak: The Asian scenario by Prof Chakrabarti Researchers Learning More About Superbug Fungus Candida Auris
Researchers Learning More About Superbug Fungus Candida Auris Candida Auris: Commensal Pathogen, Friend or Foe? - Infection Prevention and Control Aspects
Candida Auris: Commensal Pathogen, Friend or Foe? - Infection Prevention and Control Aspects
Video Mp4 Mp3Azwap.Biz
Azwap.Biz 2021-2023


 Candida auris Emergence – Dr M Chayakulkeeree
Candida auris Emergence – Dr M Chayakulkeeree Stopping the Spread of a Superfungus in Intensive Care - Dr Katie Jeffery and Dr David Eyre
Stopping the Spread of a Superfungus in Intensive Care - Dr Katie Jeffery and Dr David Eyre Candida auris: a cause for concern
Candida auris: a cause for concern Candida Auris
Candida Auris CIDRAP ASP - Candida auris, an EmergingMulti-drug Resistant Yeast
CIDRAP ASP - Candida auris, an EmergingMulti-drug Resistant Yeast Your Hospital's Next Global Outbreak
Your Hospital's Next Global Outbreak Candida auris outbreak: The Asian scenario by Prof Chakrabarti
Candida auris outbreak: The Asian scenario by Prof Chakrabarti Researchers Learning More About Superbug Fungus Candida Auris
Researchers Learning More About Superbug Fungus Candida Auris Candida Auris: Commensal Pathogen, Friend or Foe? - Infection Prevention and Control Aspects
Candida Auris: Commensal Pathogen, Friend or Foe? - Infection Prevention and Control Aspects